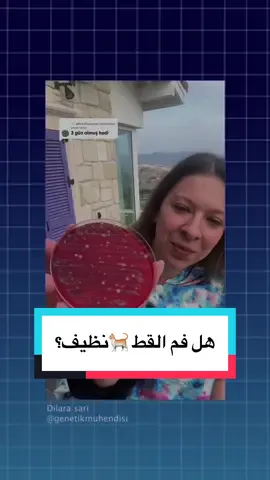
منو حلقه انظف؟ قط كلب او انسان

xazal.l
Region: IQ
Thursday 29 February 2024 16:11:55 GMT
17208
989
9
22
Music
Download
Comments
.🌷. :
🥰🥰🥰
2024-10-23 00:43:57
0
CLS63s :
💙💙💙
2024-07-31 12:24:07
0
Lost or win :
❤❤❤
2024-05-18 22:42:24
0
Hama/حەمە🖤 :
🖤🖤🖤
2024-02-29 16:17:53
0
To see more videos from user @xazal.l, please go to the Tikwm
homepage.